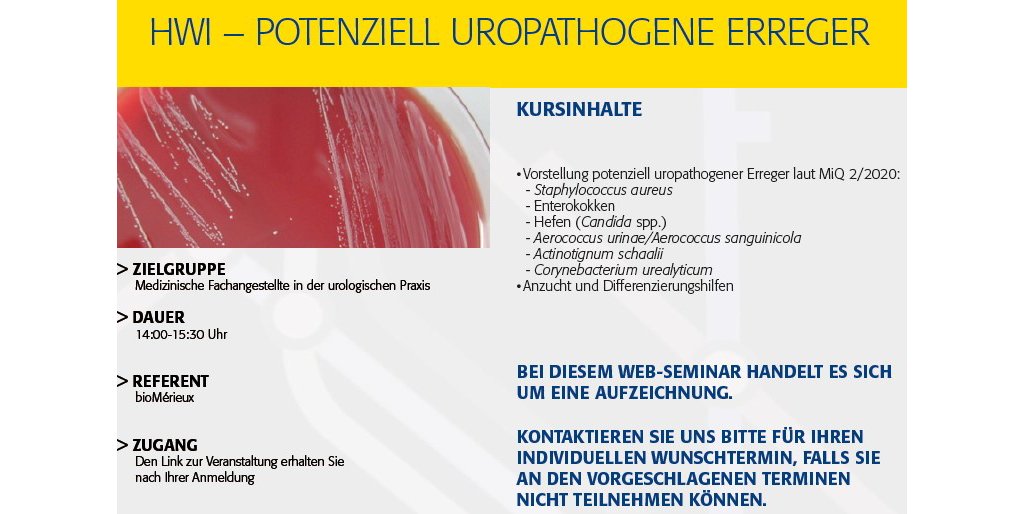

-
November 26, 2025
Intestinale Würmer (WEB261125V)
ZIELGRUPPE: Labormitarbeiter und Ärzte
-
November 27, 2025
Intestinale Protozoen (WEB271125V)
ZIELGRUPPE: Labormitarbeiter und Ärzte
-
November 27, 2025
Qualitätssicherung von Nährmedien bei der Lebensmittel- und Wasseranalytik (DIN EN ISO 11133:2020) (WEB271125N)
ZIELGRUPPE: Labormitarbeiter und Laboreiter aus der Lebensmittelindustrie
-
November 28, 2025
HWI - potenziell uropathogene Erreger (AUFZ281125)
Zielgruppe: Medinische Fachangestellte in der urologischen Praxis
Bei diesem Web-Seminar handelt es sich um eine Aufzeichnung.
-
November 28, 2025
HWI - Empfindlichkeitsprüfung - Grundlagen und Beurteilung (AUFZ281125)
Zielgruppe: Medinische Fachangestellte in der urologischen Praxis
Bei dieser Schulung handelt es sich um eine Aufzeichnung. -
Dezember 02, 2025
Grundlagen der Klinischen Mikrobiologie: Stufe 1 (GKI021225)
ZIELGRUPPE: Labormitarbeiter
-
-
Dezember 03, 2025
HWI - potenziell uropathogene Erreger (AUFZ031225)
ZIELGRUPPE: Medizinische Fachangestellte in der urologischen Praxis
-
Dezember 08, 2025
Klassifizierung von Bakterien - ein kurzer Überblick (AUFZ081225)
Zielgruppe: Einsteiger oder Wiedereinsteiger in der mikrobiologischen Diagnostik
-
Dezember 09, 2025
Grundlagen der Klinischen Mikrobiologie: Stufe 2 (GKII091225)
Zielgruppe: Labormitarbeiter/innen
Suche
Suggestions
Results